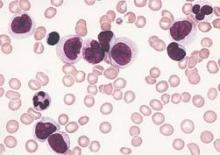

An understanding of the various molecular differences between acute myeloid leukemia (AML) particles is guiding the search for new drug combinations targeting a variety of AML cellular processes, according to research published in the New England Journal of Medicine.
After a brief overview of disease classification and prognostic factors for AML, the authors, led by Dr. Hartmut Döhner of University Hospital Ulm in Germany, described a number of new treatment strategies. These approaches include directly addressing mutant proteins by targeting mutation-specific dependencies, developing inhibitors that could cut down on the occurrence of mutations in receptor tyrosine kinase genes, and developing new epigenetic therapies based on targeting specific mutant metabolic enzymes such as IDH1 and IDH2.
Other strategies, such as antibody therapy that focuses on the development of new monoclonal antibodies targeting CD33, and new formulations of older cytotoxic agents, also are being developed or are in clinical trial stages; however, many of these developments have not yet been translated into clinical practice, the researchers noted.
“New compounds hold promise to improve treatment outcomes; however, it is unlikely that any of these compounds, when used as single agents, will cure the disease. A major challenge will be to identify predictors for a response to specific agents, which will allow for the rational design of combinatorial therapies,” they wrote.
Dr. Döhner and a coauthor disclosed ties with several pharmaceutical companies.
Read the article here.